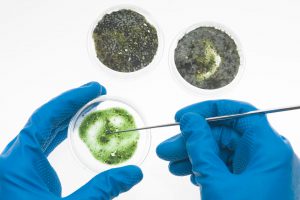

La Secretaría de Extensión Académica cuenta con una amplia gama de cursos y diplomados que se pueden impartir a solicitud de las empresas o instituciones que los requieran, los cuales son diseñados a la medida de sus necesidades.
Contamos con un extenso grupo de profesionales con formación interdisciplinaria, expertos en docencia y con experiencia en la práctica profesional.
Se requiere un mínimo de 10 asistentes.
De acuerdo con la detección de necesidades de capacitación de las áreas de recursos humanos de diversas empresas, se ha incrementado y mejorado nuestra oferta educativa, diseñando programas especializados en las áreas de Administración, Alimentos, Ambiental, Bioquímica Clínica, Farmacia, Ingeniería, Metalurgia y Química para impartirse en alguna de sus dos sedes (Ciudad Universitaria y Tacuba) o, en su caso, en las instalaciones de las mismas empresas.
Para mayor información contactar al
M. en I. Eduardo Morales Villavicencio
Teléfonos: 56.23.38.11 y 56.23.38.13
Correo: edmorvi@unam.mx
Contamos con un extenso grupo de profesionales con formación interdisciplinaria, expertos en docencia y con experiencia en la práctica profesional.
Se requiere un mínimo de 10 asistentes.
De acuerdo con la detección de necesidades de capacitación de las áreas de recursos humanos de diversas empresas, se ha incrementado y mejorado nuestra oferta educativa, diseñando programas especializados en las áreas de Administración, Alimentos, Ambiental, Bioquímica Clínica, Farmacia, Ingeniería, Metalurgia y Química para impartirse en alguna de sus dos sedes (Ciudad Universitaria y Tacuba) o, en su caso, en las instalaciones de las mismas empresas.
Para mayor información contactar al
M. en I. Eduardo Morales Villavicencio
Teléfonos: 56.23.38.11 y 56.23.38.13
Correo: edmorvi@unam.mx
La Secretaría de Extensión Académica, a través de la Coordinación de Actualización Docente (CAD), cuenta con una amplia gama de Diplomados que se pueden impartir a solicitud de las instituciones educativas públicas o privadas que los requieran, los cuales son diseñados a la medida de sus necesidades.
La Coordinación de Actualización Docente se creó con el propósito de contribuir al desarrollo de la educación en ciencias en México, en particular, en lo referente a su enseñanza. Actualmente, la CAD realiza actividades de actualización, formación y profesionalización docente (presenciales y en línea) en el campo de las ciencias naturales (Física, Química y Biología) y de las Matemáticas dirigidas a docentes en ejercicio de los diferentes niveles educativos: educación básica, media superior y superior. La CAD adapta estas propuestas a las necesidades de las instituciones educativas que las soliciten y está en disposición también de diseñar nuevos programas (conferencias, talleres, cursos y diplomados) para responder a dichas necesidades.
Para el buen logro de estas acciones, contamos con un extenso grupo de profesionales expertos con formación interdisciplinaria, tanto en el campo de las ciencias y las Matemáticas, como de la educación, con gran experiencia docente en educación básica y media superior, apoyando a profesores de estos mismos niveles. La experiencia de más de 20 años de colaborar con diversas instituciones educativas del país y de Latinoamérica avalan nuestro trabajo. Es importante mencionar que para poder impartir cualquiera de nuestros programas se requiere un mínimo de 15 asistentes.
Estos programas se pueden impartir en alguna de nuestras dos sedes (Ciudad Universitaria y Tacuba) o en las instalaciones de las mismas instituciones, tanto en la Ciudad de México como fuera de la ciudad. Algunos de estos cursos, inclusive pueden impartirse en línea o de manera semipresencial.
Les sugerimos que revisen nuestra página web y nuestra aula virtual.
Para mayor información contactar a la
M. en D. Cristina Rueda Alvarado
Coordinadora de Actualización Docente de la SEA
Teléfonos: (55) 56.23.38.11 y (55) 56 224800, extensión 84065
Página web: www.cad.unam.mx
Correo electrónico: cristina@unam.mx
Nuestra oferta educativa es la siguiente:
Diplomados Coordinación de Actualización Docente (CAD)
- Diplomado en Competencias Fundamentales para la Enseñanza de las Ciencias Naturales
- Diplomado en Competencias Fundamentales para la Enseñanza de las Ciencias Naturales para la Educación Básica
- Diplomado en Competencias Fundamentales para la Enseñanza de las Ciencias Naturales para la Educación Media Superior
- Diplomado en Enseñanza de las Matemáticas en contexto a través del Aprendizaje Colaborativo y basado en problemas para la Educación Básica
- Diplomado en Enseñanza de las Matemáticas en contexto a través del Aprendizaje Colaborativo y basado en problemas para la Educación Media Superior